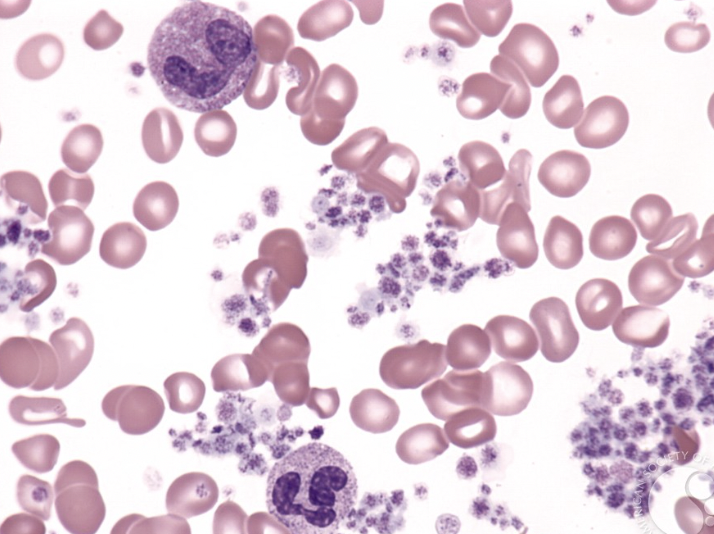
Papa Heme tweet media

Paulo Ugarte
11.1K posts

Paulo Ugarte
@paulo_ug
Soy de todo un poco menos de nada. Chapín por el mundo 🇬🇹 Internista hecho y hematólogo en proceso. Hospital Universitario de Monterrey 🇲🇽 Espacio personal

"Good night happy new year" tiraba Maduro mientras la DEA lo llevaba al calabozo. El tipo no puede salirse del personaje que hacia por television 🐐







🤡Que los laportistas pasen de utilizar a Messi para ganar elecciones a detestarlo porque les acaba de hacer el equivalente al burofax de Bartomeu regala estampas tan lamentables como estas 😵💫Laporta está por encima de todo 😂Si no eres laportista no eres culé 🤪Han enloquecido

🚨🚨 Cristiano Ronaldo: "How many World Cups did Argentina win before Messi? They're used to winning. If Portugal wins, it will shock the world." @PiersUncensored